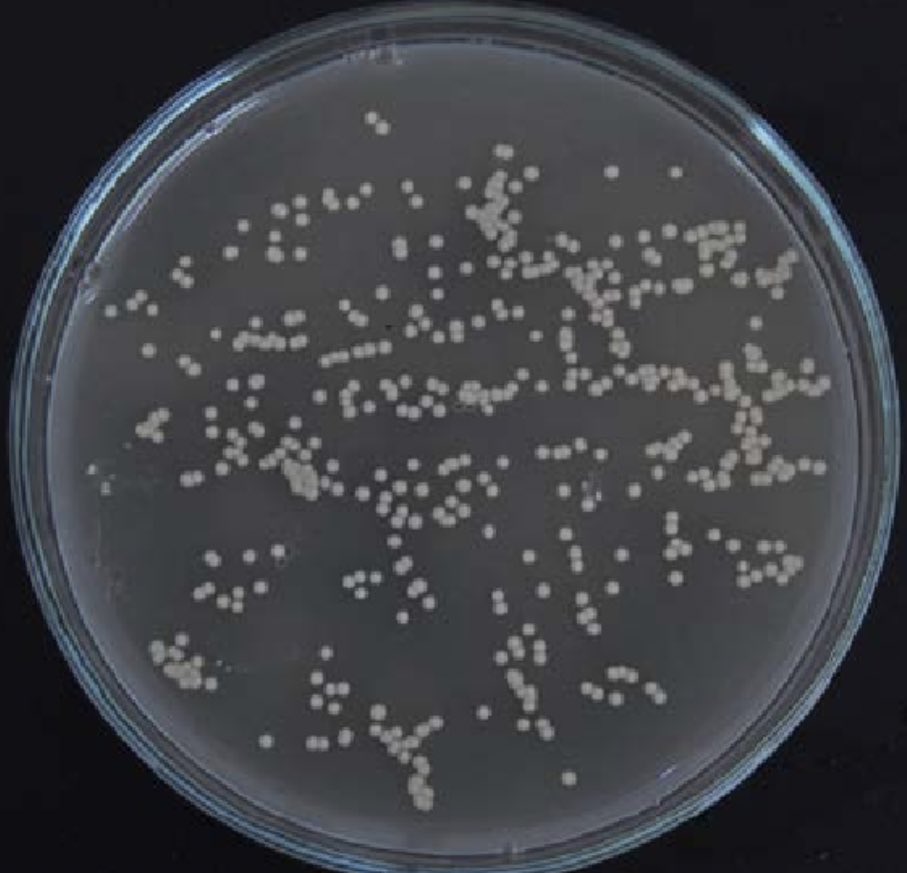

(Sebostase) ونقص في إفرازات عناصر الترطيب الطبيعية.
القشرة الدهنية: وتكون في شكل صفائح على اطراف الشعر، وعند الإمساك بها تشعر بالدهون المحتوية عليها. وأرجع العلماء أسباب حدوثها الى زيادة في افرازات الغدد الدهنية، أو بسبب نوع من الفطريات يسمى (pytiriasis) النُّخَالِيَّة
القشرة الدهنية: وتكون في شكل صفائح على اطراف الشعر، وعند الإمساك بها تشعر بالدهون المحتوية عليها. وأرجع العلماء أسباب حدوثها الى زيادة في افرازات الغدد الدهنية، أو بسبب نوع من الفطريات يسمى (pytiriasis) النُّخَالِيَّة
يتم العلاج في حالة فروة الرأس باستخدام الشامبو الحاوي على سيلينيوم سلفيد selenium sulfide أو كيتوكينازول ketoconazole. أو يمكن استخدام الشامبو الحاوي على المواد التالية: Ciclopirox olamine، Coal Tar، Zinc pyridinethione (ZPT)، Miconazole.
جاري تحميل الاقتراحات...